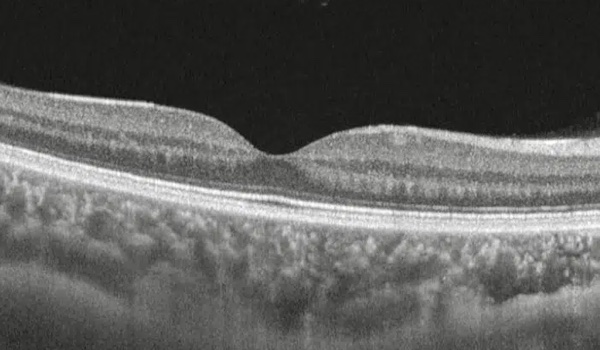

OFTALMOLOGÍA HUMANISTA
Servicios y tratamientos que ofrecemos

Revisión anual de ojo sano, y recetas para lentes
Todas las personas, aunque tengan “buena visión”, necesitan una revisión visual y ocular de manera anual, de preferencia con dilatación pupilar. Esto en especial a partir de los 40 años o cuando hay antecedentes familiares de condiciones oculares. La mayoría de estas examinaciones resultan normales, pero en un pequeño porcentaje, se detectan lesiones o enfermedades en sus estadios iniciales, cuando el tratamiento suele ser sencillo, exitoso, y resolutivo.
En Oftalmología Humanista preferimos siempre la prevención y la vigilancia.

Tratamiento multimodal para ojo seco
Si sufres de ojo seco, podemos ayudarte. Lo principal es hacerte saber que nos tomamos muy en serio tus síntomas, y entendemos que aunque muchas veces no sean graves, son molestos y pueden disminuir considerablemente tu calidad de vida. Las opciones van desde gotas un par de veces al día, hasta lentes de contacto o medicamentos especializados que controlan ciertos niveles de inflamación. Lo primero en todos los casos es un cuestionario exhaustivo y una exploración detallada, para determinar posteriormente la menor terapia posible para la resolución de los síntomas.

Terapias para blefaritis
Si la causa de las molestias o el ojo seco es inflamación activa en el borde de los párpados (blefaritis), antes de probar con medicamentos permanentes, nos encantaría brindarte consejos para una higiene efectiva de párpados, que en un gran porcentaje de los casos, suele ser suficiente para mantener la incomodidad controlada.

Abordaje diagnóstico y terapéutico de la conjuntivitis y el ojo rojo crónico
Si bien es cierto que muchas conjuntivitis en el día a día son virales, y suelen resolverse solas, dadas las múltiples posibilidades diagnósticas y las posibles consecuencias infecto-contagiosas, siempre es recomendable acudir al oftalmólogo para revisar los episodios de ojo rojo que no se resuelvan solos en unas cuantas horas.

Procedimientos menores de excisión de cuerpos extraños
Es relativamente común encontrar que el daño realizado mientras se intentaba “sacar algo que entró al ojo” es mayor o más prolongado al causado por el objeto extraño. Es preferible acudir a revisión inmediatamente (así sea una urgencia fuera de horario) y solucionar el problema, a correr el riesgo de infecciones o consecuencias a largo plazo. Usualmente la extracción es un proceso sencillo y expedito.

Tratamientos médicos de erosiones e infecciones corneales
Un rasguño o un cuerpo extraño en el ojo pueden generar úlceras en la córnea, que de no ser tratadas rápidamente, pueden dar pie a infecciones graves. Si algo parecido te sucede, podemos ayudarte en horario de oficina, o a través de nuestro teléfono de urgencias sin importar el día ni la hora.

Diagnóstico, seguimiento, y manejo quirúrgico del queratocono
Si tú o alguien de tu familia sufre de queratocono, en Oftalmología Humanista tenemos la experiencia para el diagnóstico, el seguimiento y el tratamiento en estadios tempranos, siempre priorizando la seguridad y la confianza. Algunas estrategias una vez realizado el diagnóstico incluyen el control de la inflamación de la superficie ocular, la lubricación, y la realización de entrecruzamiento de colágeno corneal (corneal collagen cross linking) como terapia para detener la progresión de la enfermedad.

Diagnóstico y tratamiento inicial de la uveitis
Sufrir de uveitis suele ser un camino largo y suntuoso, incluso frustrante. Lo más importante para el control a largo plazo de la inflamación intraocular es un diagnóstico preciso. De manera sorprendente, el arma más poderosa que tenemos para esto, es un cuestionario muy detallado que ahonda en detalles que quizá a primera vista pudieran parecer poco importantes. Una vez determinadas ciertas pistas, los exámenes de sangre o imagen únicamente confirman las sospechas, y la terapia puede ser dirigida, manejada por el oftalmólogo o por ciertos especialistas en enfermedades autoinmunes, cuando este involucra esquemas terapéuticos que incluyan al resto del cuerpo.

Terapia médica y quirúrgica del glaucoma
De todas las enfermedades de los ojos, el glaucoma es en la que más experiencia tenemos. Lo más importante en el tratamiento de esta condición es corroborar el diagnóstico y determinar si el glaucoma es leve, moderado, o severo, de acuerdo a cuánta visión se haya perdido. Las estrategias para el control serán típicamente menos agresivas en los estadios iniciales, por ejemplo, intervención láser, o gotas para reducir la presión del ojo. Entre más avanzado sea el caso, más invasivas serán las recomendaciones del médico. Sin embargo, 90% de los pacientes con glaucoma nunca requieren cirugía, y los tratamientos médicos son suficientes para prevenir la pérdida permanente de la visión. Habiendo dicho esto, ese 10% que culmina en cirugía, suele ser pacientes donde el diagnóstico se ha dado de forma tardía. Las revisiones anuales son nuestra mejor arma para el control de esta enfermedad.

Cirugía de catarata e implante de lentes intraoculares
Una cirugía de catarata en la actualidad es un proceso relativamente simple y muy seguro, con resultados positivos en aproximadamente el 99% de los casos. Su realización es bajo anestesia local en forma de gotas, y muchas veces con ligera sedación para aligerar el miedo y la ansiedad. Tiene una duración de más o menos 15 minutos, y una recuperación visual menor a una semana, aunque puede tardar 30 días en estabilizarse completamente. Se realiza primero en el ojo más afectado, y sus resultados son para toda la vida. Las cirugías más complejas tienden a ser las que se pospusieron por más tiempo. Te invitamos a apuntar todas tus dudas previo a la consulta para tener una conversación extensa que tenga como objetivo tu confianza y tranquilidad.
Si deseas saber más acerca de la cirugía de cataratas, haz clic aquí

Diagnóstico y tratamiento no quirúrgico de la diabetes ocular
En todos los casos de daño por diabetes en los ojos, tanto leves como severos, lo más importante es el control del azúcar en la sangre. Si el daño se detecta de manera temprana, cuando no ha causado síntomas, este control metabólico es el único tratamiento necesario y la labor del oftalmólogo es únicamente la vigilancia. Sin embargo, conforme el daño avanza y la retina se inflama o se presentan hemorragias, muchas veces recurrimos al tratamiento con inyecciones intraoculares (no dolorosas), o con láser para coagular las zonas más afectadas. Si el control de la glucosa no se obtiene, incluso los tratamientos descritos suelen ser insuficientes y la referencia a cirugía intraocular tiende a ser el siguiente paso.

Diagnóstico de trastornos del nervio óptico y la vía visual
Los ojos están conectados al cerebro por una serie de nervios a los que llamamos vía visual. Hay trastornos de la vía visual que son exclusivos de esa parte del sistema nervioso, y hay otros que involucran múltiples partes del cuerpo. Una exploración orientada hacia el segmento neurooftalmológico puede incluso salvar la vida del paciente. Te invitamos a acudir a visitarnos para más información acerca de los padecimientos y los tratamientos de la vía visual.

Manejo clínico y quirúrgico de orzuelos y chalazión
Tratamos orzuelos y chalaziones, inflamaciones en el párpado causadas por glándulas obstruidas, mediante tratamientos médicos o cirugía menor, según cada caso.

Manejo clínico de celulitis preseptal y postseptal
Diagnosticamos y tratamos infecciones de los tejidos que rodean el ojo, ya sea antes (preseptal) o después (postseptal) del tabique orbitario, evitando complicaciones mayores.

Evaluación y procedimientos clínicos de quemaduras corneales
Atendemos quemaduras químicas o térmicas en la córnea, brindando tratamientos urgentes para minimizar el daño y preservar la integridad visual del paciente.

Atención clínica y quirúrgica de traumas oculares
Ofrecemos diagnóstico y tratamiento inmediato de lesiones oculares por golpes, cuerpos extraños o accidentes, con enfoque clínico o quirúrgico según la gravedad.

Fotocoagulación con láser retiniano en retinopatía diabética proliferativa
Aplicamos láser en la retina para controlar vasos sanguíneos anormales causados por diabetes, reduciendo el riesgo de hemorragias y pérdida visual.

Fotodisrupción en segmento anterior (capsulotomía e iridotomías)
Usamos láser para abrir cápsulas opacas tras cirugía de cataratas (capsulotomía) o aliviar presión intraocular en casos específicos de glaucoma (iridotomía).

Cirugía de pterigión
Removemos el pterigión, un crecimiento anormal de tejido en la conjuntiva que invade la córnea, mediante una cirugía ambulatoria, estética y funcional.

Tratamiento multimodal de retinopatía diabética
Ofrecemos tratamientos combinados con láser, medicamentos intravítreos y/o cirugía para controlar complicaciones retinianas derivadas de la diabetes.

Diagnóstico y tratamiento de desprendimiento de retina
Identificamos y corregimos el desprendimiento de retina, una urgencia oftalmológica, mediante cirugía especializada para evitar la pérdida permanente de visión.

Diagnóstico y tratamiento de degeneración macular
Detectamos y tratamos esta afección que deteriora la visión central, común en personas mayores, usando medicamentos y terapias que ayudan a frenar su avance.
Tratamiento multimodal de membrana epirretiniana
Tratamos la formación de una membrana sobre la mácula que distorsiona la visión, mediante medicamentos o cirugía para mejorar la calidad visual del paciente.

Manejo clínico de agujero macular
Evaluamos y tratamos quirúrgicamente agujeros en la mácula que generan visión central borrosa o distorsionada, con técnicas que promueven su cierre y recuperación visual.

Tratamiento y seguimiento de hipertensión arterial sistémica (HAS)
Monitoreamos y tratamos los efectos de la hipertensión en los ojos, previniendo daños en la retina y otras estructuras oculares causados por presión arterial elevada.

Atención clínica y quirúrgica de desgarro de retina
Diagnosticamos y tratamos desgarros retinianos con láser o cirugía para prevenir desprendimientos mayores y preservar la visión de forma segura y eficaz.

Urgencias 24 horas
Si algo inesperado ocurre y necesitas atención oftalmológica de emergencia, no dudes en ponerte en contacto con nuestra línea de atención a cualquier horario y en cualquier día, y acudiremos a revisarte de manera inmediata. Ejemplos de situaciones que ameritan atención urgente son: Golpes en los ojos, cuerpos extraños, quemaduras químicas (cloro, sosa cáustica, aceite hirviendo, etc), dolor severo, pérdida súbita de la visión, visión doble de reciente aparición, o alteraciones relacionadas a lentes de contacto. Contamos con amplia experiencia y toda la voluntad de asistir a la brevedad.
